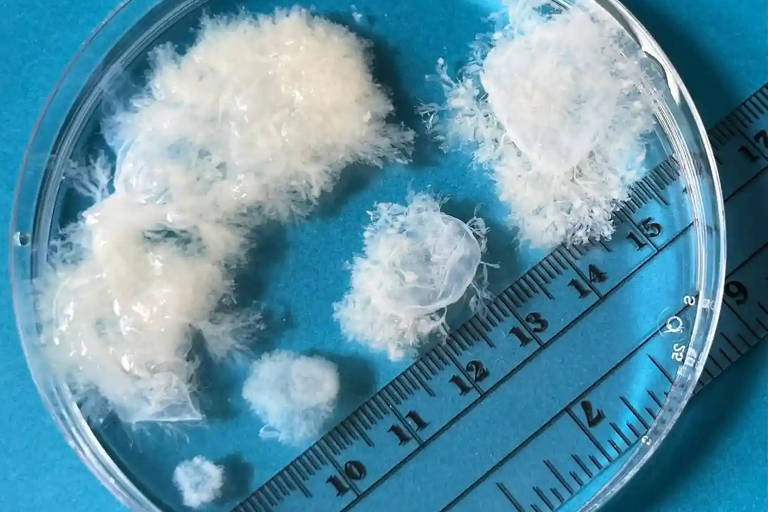
Coletas de aborto mostram os materiais de cinco a nove semanas de gestação
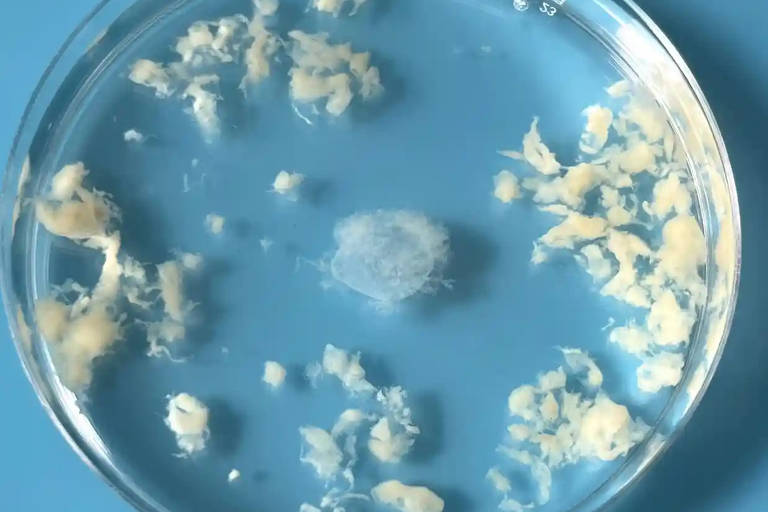
Coleta de decídua (camada funcional do endométrio) e do saco gestacional com nove semanas de gestação

Magistrada afirmou que direitos da mãe não podem se sobrepor aos do nascituro.
A comarca de Cabreúva do Tribunal de Justiça de São Paulo negou acesso ao aborto por uma mulher que gesta um feto sem chances de vida extrauterina. Em sua decisão, a magistrada responsável pelo caso afirma que o sofrimento psicológico da mãe "não pode se sobrepor ao direito à vida do feto".
Segundo o processo, que tramita em segredo de Justiça e ao qual à coluna teve acesso, dois exames de ultrassonografia e um laudo pericial atestam que o feto não tem rins e está com seus pulmões comprometidos, além de que não há líquido amniótico
"Não resta dúvida a esse perito que o caso em tela se trata de grave caso de má-formação fetal, a agenesia renal bilateral, que é incompatível com a vida extrauterina", afirmou um médico nomeado pela Justiça para a perícia. Seu relatório destaca que o diagnóstico pode ser considerado fechado, uma vez que os sinais são "claros e conclusivos".
A prova pericial solicitada pelo juízo ainda aconselha que a gravidez seja interrompida a fim de se minimizar os riscos gestacionais e "possíveis distúrbios de saúde mental" para a mulher e seus familiares. O Ministério Público de São Paulo também se manifestou em prol da realização do procedimento.
mônica bergamo
Receba no seu email as informações exclusivas da coluna Mônica Bergamo
Ambas as recomendações, no entanto, foram rejeitadas pela comarca do interior paulista, que considerou não haver "indícios suficientes" para o acolhimento do pedido.A decisão também refutou o argumento da defesa de que o caso se assemelha ao de fetos anencéfalos, em que o direito ao aborto foi garantido após decisão do Supremo Tribunal Federal (STF).
Para a juíza do caso, não há correspondência entre as duas situações nem provas de que "o feto apresente qualquer dano cerebral que lhe retire a notória capacidade de sentir ou de sofrer".
A mulher gestante recorreu, e seu caso está apto a receber uma nova decisão desde a última terça-feira (6). A sentença será dada por um desembargador da 10ª Câmara de Direito Privado do Tribunal de Justiça de São Paulo.
Embora a magistrada faça menções a supostos direitos do feto, eles não estão previstos na Constituição Federal.
Referências aos "direitos do nascituro" constam no Código Civil, mas são frequentemente usadas em projetos que tramitam no Congresso e buscam dar ao embrião os mesmos direitos de uma pessoa nascida, além de restringir as possibilidades de aborto já previstas em lei —em casos de gravidez após estupro, de feto anencéfalo e quando há risco de morte materna.
Segundo especialistas, o objetivo do uso da expressão é tentar conferir determinados direitos fundamentais ao embrião, em conflito com os da gestante.
DEDICATÓRIA
As advogadas Gabriela Araujo, Maíra Recchia e Priscila Pamela Santos, sócias do escritório Araujo Recchia Santos Sociedade de Advogadas, realizaram um jantar em homenagem à advogada Daniela Teixeira no restaurante Cantaloup, em São Paulo, na semana passada. As advogadas Sheila de Carvalho e Thayná Yared compareceram, assim como a conselheira da OAB Daniela Libório e a professora da USP e ex-primeira-dama de São Paulo Ana Estela Haddad.